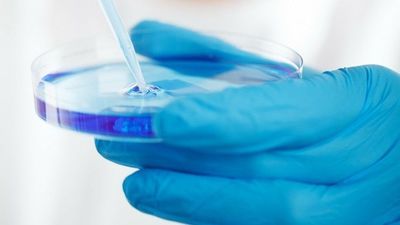
Koronawirus coraz bliżej Polski. Pierwsze przypadki w Rumunii, Estonii i Norwegii

Pierwszy przypadek koronawirusa w Polsce jest już potwierdzony? Zarażona wirusem ma być kobieta, która znajduje się w szpitalu w Łodzi. Tak podaje Dziennik Łódzki. Ministerstwo Zdrowia jednak na razie zaprzecza, że w Polsce mamy już koronawirusa.

W szpitalu im. Biegańskiego w Łodzi przebywa młoda kobieta, u której pierwsze badanie w kierunku zakażenia koronawirusem wyszło pozytywnie. Niedawno wróciła z Tajlandii.
– Na razie jest to jednak wynik wątpliwy, nie możemy opierać się na jednym badaniu. Dzisiaj została wysłana do badania kolejna próbka. Czekamy na wyniki, które będą znane prawdopodobnie w godzinach popołudniowych – informuje Dorota Gajewska z Łódzkiego Urzędu Wojewódzkiego. – Najważniejsze jest to, że kobieta czuje się bardzo dobrze.
Jak informuje Dziennik Łódzki, chodzi o 25-latkę, która była miesiąc w Tajlandii i już tam miała się źle czuć. Miała objawy infekcji z silnymi dusznościami. Do Polski miała wrócić w sobotę i sama zgłosiła się do szpitala. Jak donosi gazeta, inspekcja sanitarna ma badać z iloma osobami kobieta miała kontakt.
Ministerstwo Zdrowia na razie jednak oficjalnie zaprzecza, że w Polsce mamy już koronawirusa. "Nie ma potwierdzonego przypadku koronawirusa" – informują przedstawiciele resortu na Twitterze.
Przed koronawirusem drży cały świat. Co należy wiedzieć?
Wideo: x-news